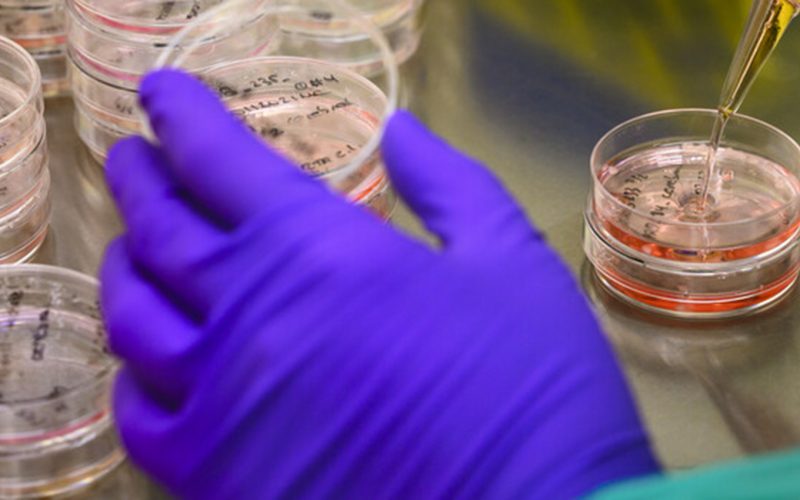
Organoids in a Petri dish

Five researchers from UMC Utrecht have been awarded a prestigious Vidi grant of up to 850,000 euros. This was announced by the Dutch Research Council (NWO) on Thursday, October 24.
A total of 102 researchers will receive a Vidi grant from the NWO. This grant allows them to develop their own innovative line of research and set up or expand a research group over the next five years. The following researchers and projects have been awarded:
Predictive artificial intelligence is rapidly advancing in healthcare to support doctors and patients in making important medical decisions. Just as cars need a general periodic inspection (MOT), it is also important to periodically test artificial intelligence. If it is still good enough for use and if necessary, carry out the appropriate maintenance. In this project, I will develop the MOT for artificial intelligence in healthcare.
Chronic pain affects 1 out of 5 people. After recovery from an infectious disease (e.g. COVID-19), patients often continue to suffer from pain. This pain is difficult to treat. Currently, we do not know who is more prone to develop chronic pain. Preliminary evidence points to a disturbed neurometabolism promotes chronic pain. My aim is to identify how neurometabolic alterations link to long-lasting neuronal activity and the duration of post-viral pain. In addition, I also aim to test whether restoring these alterations dampen neuronal hyperactivity. This knowledge may create novel options to prevent and treat chronic pain.
Errors in a single gene cause up to one quarter of the most severe kidney diseases. Yet, there are few targeted treatments for these monogenic kidney diseases. Many more types of these monogenic kidney diseases almost certainly remain to be detected. Researchers have built up a wealth of data and insights over the past decade. This will be used to combine cutting-edge DNA analysis and kidney cell models to shed much-needed light on monogenic kidney diseases. This is expected to improve diagnostics and enable effective individualized treatments, ultimately improving patient care and quality of life.
Parents who receive the news that their unborn child has a severe congenital anomaly often face mental health challenges, both during and after birth. Parental well-being strongly influences child development. This study aims to develop a personalized psychosocial support intervention during pregnancy, assessing its efficacy in reducing parental stress. Addressing stress and preparing parents for post-birth may positively impact the child’s long-term development. By reducing parental stress and adequately preparing parents for the post-birth period, we anticipate a positive impact on the long-term development of the child.
Diffusion MRI helps understand diseases and treatment effects by imaging properties of cells without having to take a biopsy. This project aims to improve the accuracy of these estimates by combining diffusion MRI with electron microscopy and computer simulations. By using powerful MRI machines, studying organoid models, and developing efficient computer programs, the researchers hope to better understand brain tumours in children and ultimately improve their treatment.